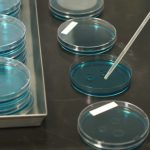

Aktuelle Ausbrüche der Geflügelpest in Österreich
Im aktuellen HPAI2023 AGES Newsletter werden alle bestätigen Geflügelpest Ausbrüche dargestellt. Insgesamt sind im Zeitraum von 01.11.2022 bis zum 25.01.2023 bisher 46 bestätige positive Fälle der hochpathogenen Geflügelpest vom Subtyp H5N1 festgestellt worden. Die Zahl der Ausbrüche und Verdachtsfälle ändert sich laufend – die Angaben sind daher ohne Gewähr. In der Grafik sind alle Gebiete mit erhöhtem und mit stark erhöhtem Geflügelpestrisiko eingezeichnet.
In Niederösterreich und Wien wurden bisher 38 Wildvögel positiv auf das Virus getestet. In Oberösterreich und der Steiermark jeweils ein Wildvogel.
Am 13.01.2023 wurde die hochpathogene Form der Geflügelinfluenza in einer privaten Geflügelhaltung mit drei Gänsen, elf Enten und zwanzig Hühnern, in Oberösterreich (Bezirk Braunau) nachgewiesen.
Zwei weitere Geflügelpestfälle wurden mit 19.01.2023 gemeldet. Eine private Haltung mit 30 Hühnern und 16 Enten im Bezirk Linz-Land und eine landwirtschaftlichen Hühnerhaltung im Bezirk Wels-Land, mit insgesamt 550 Tieren, ist von der Geflügelpest betroffen.
Auch bei einem Tierpark in Tirol konnte H5N1 nachgewiesen werden. Ein Pelikan und fünf Schwäne sind verendet. Ein weiterer Schwan musste getötet werden.
Mit heute bestätigt sich ein weiterer Fall in einer landwirtschaftlichen Hühnerhaltung in der Steiermark mit 2600 Legehennen.